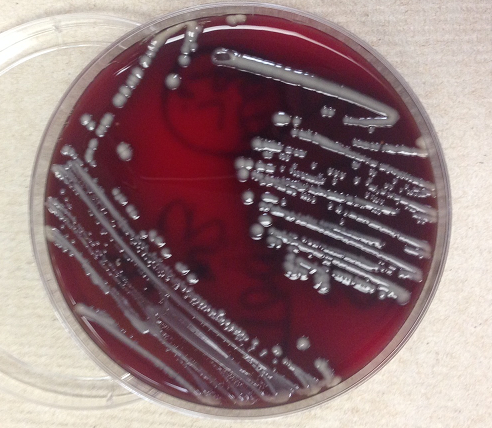

Case History:
A 38 year old man with history of secondary progressive multiple sclerosis complicated by neurogenic bladder requiring intermittent straight catheterization presented with fevers, chills, and weakness. Clinical evaluation revealed hypotension and leukocytosis concerning for sepsis. His urinalysis was positive for 3+ blood, 1+ leukocyte esterase and nitrites. Urine was sent to our laboratory for culture and grew bacteria with the below gram stain and colony morphology.

Laboratory identification:
Klebsiella and Raoultella both are gram negative bacilli that form lactose fermenting, yellow, mucoid bacterial colonies. The bacterial colonies appear mucoid because of the bacteria’s polysaccharide capsule. Distinguishing these two types of bacteria requires molecular analysis as their morphology can be identical. In our initial identification process, only one type of bacteria was detected on the urine culture. Given the gram stain and colony morphology, our differential included Klebsiella, Enterobacter, and Roaultella. The bacteria was verified as Roaultella species using mass spectrometry. However, our laboratory also received two sets of blood cultures which showed the same morphology as above but the bacteria was identified as K. oxytoca. This prompted a review of the urine culture in which a subtle second bacterial colony morphology was seen and confirmed as K. oxytoca.
Discussion:
In summary, our patient had a urinary tract infection caused by Roaultella and Klebsiella which was the source of the patient’s sepsis. Only the Klebsiella was detected in his blood stream. Raoultella and Klebsiella are both gram negative, oxidase negative, non-motile, capsulated, facultative anaerobic bacilli within the Enterobacteriaceae family. Raoultella was initially classified within the Klebsiella genus, but reclassified based on comparative analysis of the 16S rRNA gene and rpoB gene which encodes the β subunit of bacterial RNA polymerase. Members of the Raoultella genus include R. electrica, R. terrigena, R. planticola, and R. ornithinolytica and are found in the environment, specifically in plants, soil, and water. Raoultella species are rare in human disease but have been documented to cause bacteremia, urinary tract infection, conjunctivitis and cholecystitis.
Klebsiella causes human disease much more frequently than Roaultella. Klebsiella are part of human oropharynx and gastrointestinal flora that act as opportunistic pathogens. Mode of transmission may occur endogenously or through person to person spread, hence nosocomial infections are common. K. oxytoca and K. pneumoniae are the most frequently implicated species in human disease and may cause a wide spectrum of infections such as urinary tract infections, respiratory infections, enteritis, meningitis and bacteremia.
For our patient, we reported antibiotic sensitivities that were susceptible to both types of bacteria. The patient was treated with ceftriaxone and then transitioned to cefpodoxime with resolution of his urosepsis. In general, Raoultella’s susceptibility to antimicrobial agents are not well studied and should be based on the antibiotic sensitivities of each strain. In contrast, Klebsiella is well documented to have increasing antimicrobial resistance. Most clinical strains are resistant to ampicillin, carbenicillin and ticarcillin as well as extended spectrum beta-lactam drugs. Resistance to beta-lactam drugs is the result of Klebsiella bacteria that harbor plasmids which produce beta-lactamase enzymes.
-Jill Miller, MD is a 2nd year anatomic and clinical pathology resident at the University of Vermont Medical Center.
-Christi Wojewoda, MD, is the Director of Clinical Microbiology at the University of Vermont Medical Center and an Assistant Professor at the University of Vermont.
